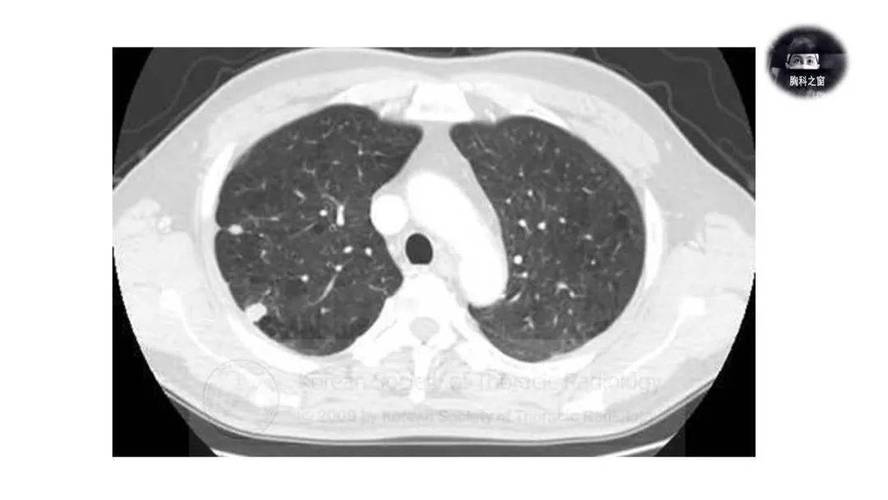
类风湿肺部类风湿结节

第一部分:总览 - 类风湿关节炎与肺部的关系
首先需要明确的是,类风湿关节炎是一种全身性的自身免疫性疾病,它不仅仅影响关节,还会影响到身体的其他器官,其中肺部是最常受累的器官之一。
(图片来源网络,侵删)
据统计,约 20%-50% 的RA患者在病程中会出现不同程度的肺部病变,这些肺部病变可以在关节炎出现之前、之后或同时发生,并且是RA患者发病和死亡的重要原因之一。
第二部分:类风湿肺部病变
“类风湿肺部”是一个总称,它涵盖了多种不同的肺部疾病,以下是几种最常见的形式:
间质性肺病
这是RA肺部病变中最常见、也最受关注的一种。
- 什么是ILD? 就是肺部的“间质”(肺泡之间的组织,负责气体交换)发生了炎症和纤维化(疤痕化),这就像海绵被逐渐变硬,导致肺部弹性下降,无法有效地进行氧气交换。
- 症状:
- 早期可能没有明显症状,或只在活动后感到气短、干咳。
- 随着病情进展,气短和咳嗽会加重,甚至在休息时也感到呼吸困难。
- 可能伴有乏力、体重下降等全身症状。
- 严重性: RA-ILD是RA患者预后不良的主要指标之一,病情可能进展迅速,需要积极治疗。
胸膜炎
- 什么是胸膜炎? 指覆盖在肺表面(脏层胸膜)和内胸壁(壁层胸膜)的胸膜发生了炎症。
- 症状:
- 胸痛 是最典型的症状,通常是尖锐的、针刺样的疼痛,在深呼吸、咳嗽或打喷嚏时会明显加重。
- 如果炎症导致胸腔积液(胸水),患者可能会感到更严重的气短。
- 检查: 胸部X光或CT可能显示有胸膜增厚或胸腔积液。
类风湿肺结节
这就是您问题中提到的“类风湿结节”在肺部的表现,我们将在下一部分详细讲解。

(图片来源网络,侵删)
其他较少见的肺部表现
- Caplan综合征(卡普兰综合征): 指患有RA的矿工(尤其是煤矿工人)同时患有尘肺病(如煤工尘肺),其肺部会形成一种特殊的、快速进展的类风湿结节。
- 闭塞性细支气管炎: 一种小气道的阻塞性疾病,导致气流受限,主要症状是进行性的气短和咳嗽。
- 肺动脉高压: 肺部血管压力升高,导致右心负荷加重,最终可导致右心衰竭,表现为活动后严重气短、乏力、胸痛等。
第三部分:类风湿结节
什么是类风湿结节?
类风湿结节是RA的特征性表现之一,由慢性炎症组织聚集而成,是免疫系统攻击自身组织的产物。
- 外观: 通常质地较硬,没有痛感(有时有压痛),可以移动。
- 常见位置: 最常出现在关节的突起部位,如手肘鹰嘴、手指关节、脚后跟等。
- 肺部结节: 当这些结节出现在肺部时,就称为“肺内类风湿结节”或“类风湿肺结节”。
类风湿肺结节的特点
- 发生频率: 相比于皮下结节,肺内结节的发生率要低得多,约占RA患者的1%-5%。
- 影像学表现: 在胸部X光或CT上,它们通常表现为:
- 单发或多发 的圆形或类圆形阴影。
- 边界清晰,密度均匀。
- 大小不一,可以从几毫米到几厘米。
- 好发于肺部的外周(胸膜下区域)。
- 症状: 大多数肺内类风湿结节没有明显症状,常常是在因其他原因做胸部CT时偶然发现的,少数情况下,如果结节较大、数量多或靠近气管,可能会引起咳嗽、胸痛或咯血(痰中带血)。
类风湿肺结节与间质性肺病的区别
这是一个非常重要的区别,很多人会混淆:
| 特征 | 类风湿肺结节 | 间质性肺病 |
|---|---|---|
| 病变性质 | 局限性的肿块/团块(肉芽肿) | 弥漫性的组织炎症和纤维化 |
| 影像学 | 边界清晰的圆形“影子” | 弥漫的网格状、磨玻璃状或蜂窝状阴影 |
| 症状 | 通常无症状,或仅有轻微咳嗽、胸痛 | 进行性加重的呼吸困难和干咳 |
| 预后 | 相对良好,但需监测有无变化或癌变 | 预后较差,是导致RA患者死亡的主要原因之一 |
| 治疗 | 通常无需特殊治疗,若过大或有症状可手术切除或用免疫抑制剂 | 必须积极治疗,需使用糖皮质激素、免疫抑制剂等 |
简单比喻: 肺结节就像肺里长了几个“石头”,而ILD则是整个肺的“土壤”都变硬了。
第四部分:诊断与治疗
如何诊断?
医生会结合以下信息进行综合判断:
- 病史: 明确的RA病史。
- 症状: 出现上述的呼吸道症状。
- 影像学检查: 胸部高分辨率CT 是诊断肺部病变最关键的工具,可以清晰地显示结节、ILD、胸膜炎等不同病变。
- 肺功能检查: 评估肺的通气功能,对于诊断ILD非常重要。
- 实验室检查: 血常规、炎症指标(血沉、C反应蛋白)、自身抗体等。
- 支气管镜或肺活检: 当诊断不明确时,可能需要通过支气管镜或手术取一小块肺组织进行病理检查,这是诊断的“金标准”。
如何治疗?
治疗的核心是积极控制原发病——类风湿关节炎本身。
-
控制RA活动度:
- 使用改善病情抗风湿药,如甲氨蝶呤、来氟米特等。
- 对于中重度患者,生物制剂(如TNF-α抑制剂、JAK抑制剂等)是控制病情、延缓肺部病变进展的关键。
-
针对肺部病变的治疗:
- ILD: 通常需要使用糖皮质激素联合免疫抑制剂治疗,严重的RA-ILD可能需要更强效的药物。
- 胸膜炎/胸腔积液: 主要以治疗RA为主,如果积液量大导致呼吸困难,可能需要穿刺抽液。
- 肺结节:
- 无症状、小结节: 通常定期观察(如每6-12个月复查一次CT)即可。
- 有症状或快速增大: 可能需要调整免疫抑制剂治疗。
- 难以与肺癌鉴别或引起严重并发症: 可能需要手术切除。
-
生活方式管理:
- 戒烟: 至关重要! 吸烟会显著增加RA发病风险,并加重肺部病变的进展。
- 预防感染: 肺部功能下降后更容易感染,要注意保暖和避免接触呼吸道感染患者。
- 肺康复训练: 在医生指导下进行呼吸锻炼,有助于改善呼吸功能。
- 类风湿肺部病变是RA的常见全身表现,形式多样,其中间质性肺病最为严重。
- 类风湿肺结节是其中一种相对良性的、局限性的表现,通常无症状,与弥漫性的间质性肺病有本质区别。
- 关键在于早期识别和诊断,RA患者应定期进行肺部检查,尤其是在出现呼吸道症状时。
- 治疗的核心是控制好类风湿关节炎,遵从风湿免疫科医生的指导,坚持规范用药,并保持健康的生活方式。
如果您或您的家人是RA患者,并伴有呼吸道症状,请务必及时告知您的风湿科医生,并进行必要的肺部检查。




